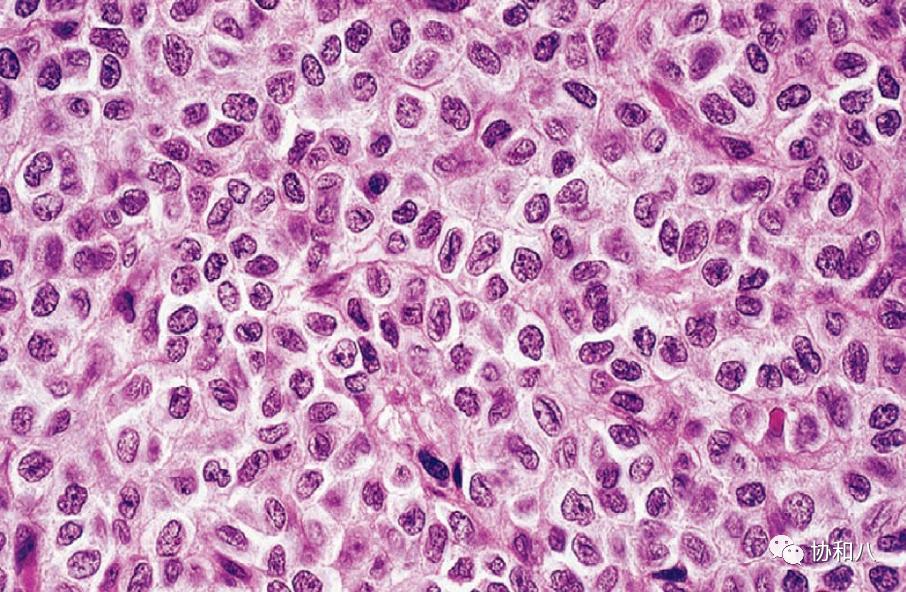
复习这些名解时总觉得怪饿的|协和八·脑洞大开

小编按:
都说和医学生一起吃饭是个修罗场,吃个火锅也堵不住他们的嘴,一边吃一边给你讲这是猪/牛/羊/鸡/鸭身上的啥啥器官,吃碗板面也得跟你说说猪带绦虫跟这碗面如何如何相似,甭管啥美味,瞬间就不香了有没有!想减肥的朋友们,不考虑多请请身边的医学生朋友们吃饭吗?
自古以来,学医的人里都不乏吃货,咱也不知道过去的这些大佬们第一次看到某种病变或征象时,为啥思绪就飘向了飘香的餐桌,快乐的果园,用食物命名的这些医学名词,可让无数当今的医学生们,在深更半夜苦读背诵名词解释时内心不禁长叹:我!好!饿!
~西餐篇~1.干酪样坏死Caseous necrosis:
结核菌感染菌量多、毒力强,机体抵抗力低或变态反应强烈时,病灶可发生干酪样坏死。坏死灶由于含脂质较多(来自破坏的结核杆菌和脂肪变性的单核细胞),病变呈淡黄色、均匀细腻,质地较实,状似奶酪,故称干酪样坏死。

左滑高能预警
2. 巧克力囊肿:
受卵巢分泌激素影响,异位子宫内膜产生周期性反复性出血,如异位发生在卵巢,反复出血可导致卵巢体积增大,形成囊腔,内含黏稠的巧克力状液体,称巧克力囊肿。

左滑高能预警
3. 牛奶咖啡斑:
神经纤维瘤病(Neurofibromatosis,NF)的典型皮肤表现,表现为平坦、均匀的色素沉着斑,在NF患者出生后1年内陆续出现,颜色浅棕如牛奶咖啡,故名牛奶咖啡斑。

左滑高能预警
4. 果酱样大便:
因粪便中混有粘液和血液,导致粪便外观呈果酱样,常见于肠套叠与阿米巴痢疾的患者。

左滑查看果酱
5. 咖啡豆征 Coffee bean sign:
不完全性绞窄性肠梗阻时,气体可以通过近端梗阻点进入,却不能排出,以致闭襻肠曲明显扩大,闭襻肠曲的内壁因水肿而增厚且相互靠扰,形成一条致密线状影,形似咖啡豆。

左滑高能预警
6. 燕麦细胞癌Oat cell carcinoma:
小细胞肺癌在镜下表现为小圆形的癌细胞,细胞质少或无,细胞一端稍尖,似燕麦,故也称燕麦细胞癌。

左滑高能预警
7. 牛肉舌:
常见于巨幼细胞性贫血,表现为舌粘膜绛红色如生牛肉状。

左滑高能预警
8. 面包和奶油心包炎Bread and butter pericarditis:
纤维素性和浆液纤维素性心包炎时,由于纤维素或浆液与纤维素渗出,导致心脏表面形成无数绒毛状纤维蛋白,外观表现一如绒毛满布,故称绒毛心,也似涂抹在面包片上的奶油,又称面包和奶油心包炎。

左滑高能预警
9. 胡桃夹综合征:
位于腹主动脉和肠系膜上动脉之间的左肾静脉受压,导致镜下血尿和肉眼血尿,腹主动脉和肠系膜上动脉如同胡桃夹,左肾静脉如同被压的核桃。

左滑高能预警
10. 葡萄酒样痣:
又名鲜红斑痣或毛细血管扩张痣,常在出生时或出生后不久出现,好发于面、颈和头皮,大多为单侧性,偶为双侧性,有时累及黏膜。损害初起为大小不一或数个淡红、暗红或紫红色斑片,呈不规则形,边界清楚,不高出皮面,可见毛细血管扩张,压之部分或完全褪色,表面平滑。

左滑高能预警
11. 咖啡豆样细胞核Coffee bean nuclei:
成人卵巢颗粒细胞瘤(Granulosa cell tumor)的镜下表现为大小一致的小瘤细胞,椭圆形或多角形,细胞质少,细胞核见核沟,状如咖啡豆。
左滑高能预警
12. 番茄奶酪样视网膜病变:
巨细胞病毒(Cytomegalovirus,CMV)感染患者的眼底改变,黄白色的视网膜坏死区域与红色的陈旧出血点状似番茄奶酪。是艾滋病患者最常见的眼部机会性感染,眼底表现为棉絮斑到融合的视网膜全层坏死伴血管炎,受累区域视网膜血管变细,最终呈白线。临床表现为视力下降,黑影飘动、闪光感、轻度视物模糊。

左滑高能预警
13. 蓝莓松饼疹:
蓝莓松饼疹是一种新生儿的皮肤病理表现,常常是由于母亲在怀孕时感染风疹病毒,临床表现为紫红斑(红色或紫色的皮肤变色,而不会因按压而变白)。先天性风疹综合症(Congenital rubella syndrome,CRS)的经典三联征为耳聋,眼睛异常和先天性心脏病。

左滑高能预警!左滑高能预警!左滑高能预警!
14. 肉豆蔻/槟榔肝:
肉豆蔻肝为肝脏慢性被动充血性改变,也被称为充血性肝病,常常是充血性心力衰竭的合并表现,肝脏静脉网络充满了血液,使肝脏看上去像肉豆蔻碎。如果心脏功能无法恢复,则肝脏会永久受损,从而导致纤维化,即病变组织的疤痕。

左滑高能预警
15. 凤尾鱼酱样脓液Anchovy sauce abscess pus:
常见于阿米巴肝脓肿,可见于脓液和痰液。与较低的社会经济状况,营养不良,慢性酒精中毒和自左向右分流的房间隔缺损相关。肺是仅次于肝的第二常见的阿米巴病肠外部位,感染通常通过阿米巴肝脓肿的扩散而扩散到肺部,但是感染也可能通过血行扩散直接从原发性肠病扩散至胸腔。临床表现为发热、咯血、肝肿大、胸腔积液、脓胸等。

左滑高能预警
16. 爆米花细胞popcorn cell:
又称Reed-Sternberg(RS)细胞,见于淋巴细胞为主型霍奇金淋巴瘤,这种多核细胞的形态特点为细胞体积大,胞核皱折、多分叶状,染色质稀少,有多个小的嗜碱性核仁,胞浆淡染,B淋巴细胞标志物CD20阳性。

左滑高能预警
17. 意大利面肉球:
在诊断花斑癣(马拉色菌引起的表浅真菌感染)时,在氢氧化钾涂片镜检下,可观察到菌丝链和大量酵母细胞,这种组合被描述为“ 意大利面条和肉丸”。

左滑高能预警
~中餐篇~1.豆渣样白带:
豆渣样或凝乳样白带,伴外阴奇痒难忍,即使是在大众场合也禁不住用手揉擦外阴以减轻痒感。常见于念珠菌感染的霉菌性阴道炎。

左滑高能预警
2. 酱油尿:
往往是胆红素尿的临床表现,胆红素尿原因常见两种情况:1)胆道梗阻。2)溶血性贫血,即体内溶血。胆道梗阻的常见情况,见于胆道结石、胆道感染、胆道肿瘤引起来的胆道梗阻,胆红素过多排入尿液引起来的酱油色尿,即胆红素尿。

左滑高能预警
3. 动脉粥样硬化atherosclerosis,AS:
是冠心病、脑梗死、外周血管病的主要原因。脂质代谢障碍导致受累动脉病变从内膜开始,先有脂质和复合糖类积聚、出血及血栓形成,进而纤维组织增生及钙质沉着,并有动脉中层的逐渐蜕变和钙化,导致动脉壁增厚变硬、血管腔狭窄。由于在动脉内膜积聚的脂质外观呈黄色粥样,因此称为动脉粥样硬化。

左滑高能预警
4. 蛋花汤样便:
婴儿蛋花汤样大便属于大便异常症状,这可能是肠道炎症、轮状病毒感染、消化不良或是肚子着凉而导致的。

左滑查看蛋花汤
5. 米汤样便:
牛奶色或米汤样便是由于肠杆菌科部分致病菌所感染引起的症状之一。 引起腹泻的病因比较复杂,有细菌、病毒、寄生虫等,某些化学药品亦可导致腹泻,常见于细菌性痢疾,由志贺菌属引起,腹泻以脓血或黏液状便较常见。

左滑查看米汤
6. 鸡皮病(毛囊角化症):
是一种常染色体显性遗传病,也可与甲状腺功能不全或维生素A缺乏相关,临床表现出现在四肢伸侧的皮肤砂纸样粗糙或鸡皮样外观,可见分散的、针头大、尖顶、毛囊性丘疹,中心有角质栓,多为正常肤色或暗红色,一般无自觉症状,偶有轻度痒感。

左滑高能预警
~蔬菜瓜果篇~1.樱桃红斑:
视网膜中央动脉阻塞的典型体征,因眼底动脉血运中断,视网膜后极部出现弥漫性灰白色水肿,眼底黄斑中心凹处,在周围灰白色水肿区的陪衬下,呈现醒目的樱桃红斑。

左滑高能预警
2. 樱桃状血管瘤:
樱桃状血管瘤也称为Campbell de Morgan斑,是常见于中年和较年长成人患者的成熟毛细血管增殖。描述:多发性,多位于躯干。为圆顶状,直径0.1-0.4cm,光滑、质硬、鲜红色到深红色的丘疹。通常压之褪色。若病变含较多纤维成分则压之不褪色。

左滑高能预警
3. 杨梅/草莓舌:
儿童川崎病、猩红热等疾病的典型表现。(八年制儿科学第3版中,对川崎病和猩红热的舌表现,均描述为“杨梅舌”。)描述:舌面清净呈牛肉样深红色,舌刺红肿明显,突出于舌面以上。为丝状乳头坏死脱落和发炎舌组织剥脱的结果。

左滑高能预警
4. 葡萄串征:
常用于描述囊状支气管扩张(图1&2)的典型CT表现,也见于结肠含气囊肿(图3)。描述:簇状/串状囊腔呈葡萄串样。

左滑高能预警
5. 葡萄胎:
葡萄胎是指妊娠后胎盘绒毛滋养细胞增生,间质高度水肿,形成大小不一的水泡,水泡间相连成串,形如葡萄,亦称水泡状胎块(Hydatidiform mole,HM)。

左滑高能预警
6. 橘皮样变:
乳腺癌特征性体征。由于癌肿机械性阻塞皮肤淋巴管引起淋巴水肿,伴毛囊和毛囊孔下陷,皮肤变厚,局部乳房皮肤呈橘子皮状。

左滑高能预警
7. 梨形心:
又称“二尖瓣”型心。由于严重的二尖瓣狭窄,左心房及右心室增大,左心房耳部突出,右心房轻度增大。在X线平片上显示为“梨形心”。

左滑高能预警
8. 西瓜胃:
为胃窦血管扩张症(Gastric antral vascular ectasias,GAVE)在胃镜下的特征性表现。描述:从幽门放射至胃窦的纵向扁平红色条纹,与西瓜表面的条纹类似。红色条纹是扩张的囊状黏膜血管。

左滑高能预警
9. 草莓样宫颈:
见于阴道毛滴虫引起的滴虫性阴道炎。描述:宫颈点状出血。

左滑高能预警
10. 苹果核征:
最常见于结肠癌。描述:在钡剂灌肠检查时出现结直肠局部狭窄,这个狭窄表现为两端呈肩状,中央的管腔狭窄,并有粘膜破坏,边缘不规整,形似被吃剩的苹果核。肿瘤沿肠壁环周浸润超过肠管周径的2/3时,可产生本征象。其两端为环堤形成的隆起边界,中央的管腔狭窄段为癌性溃疡所形成的癌性隧道。

左滑高能预警
11. 菜花耳:
这是耳朵反复受伤后发生的畸形。耳朵受到足够的打击,血液供应和下面的软骨支架受到破坏,直至愈合过程正常进行,从而产生了一种外观上类似于菜花的生长。

左滑高能预警
12. 草莓胆囊:
草莓胆囊被人们称为胆囊胆固醇变性,是外科手术中发现胆囊壁中胆固醇过多的外科手术发现。众所周知,胆囊可以储存和释放胆汁(在肝脏中产生),这有助于我们乳化并随后消化饮食中的脂肪,胆囊的斑点状外观是由于胆固醇的沉积,类似草莓的种子。

左滑高能预警

疫情期间
不知道各位同学都胖瘦了几斤
与其每天盼星星盼月亮似的盼开学
不如现在就一起脑洞大开
回想一下自己医学生涯中还见过哪些食物相关医学名词吧
咱们评论区见!
*图片来源于网络
作者:大长杆君 覆萝子木 如日中天手绘:小果排草 如日中天编辑:大长杆君质控:闲闲闲兔
